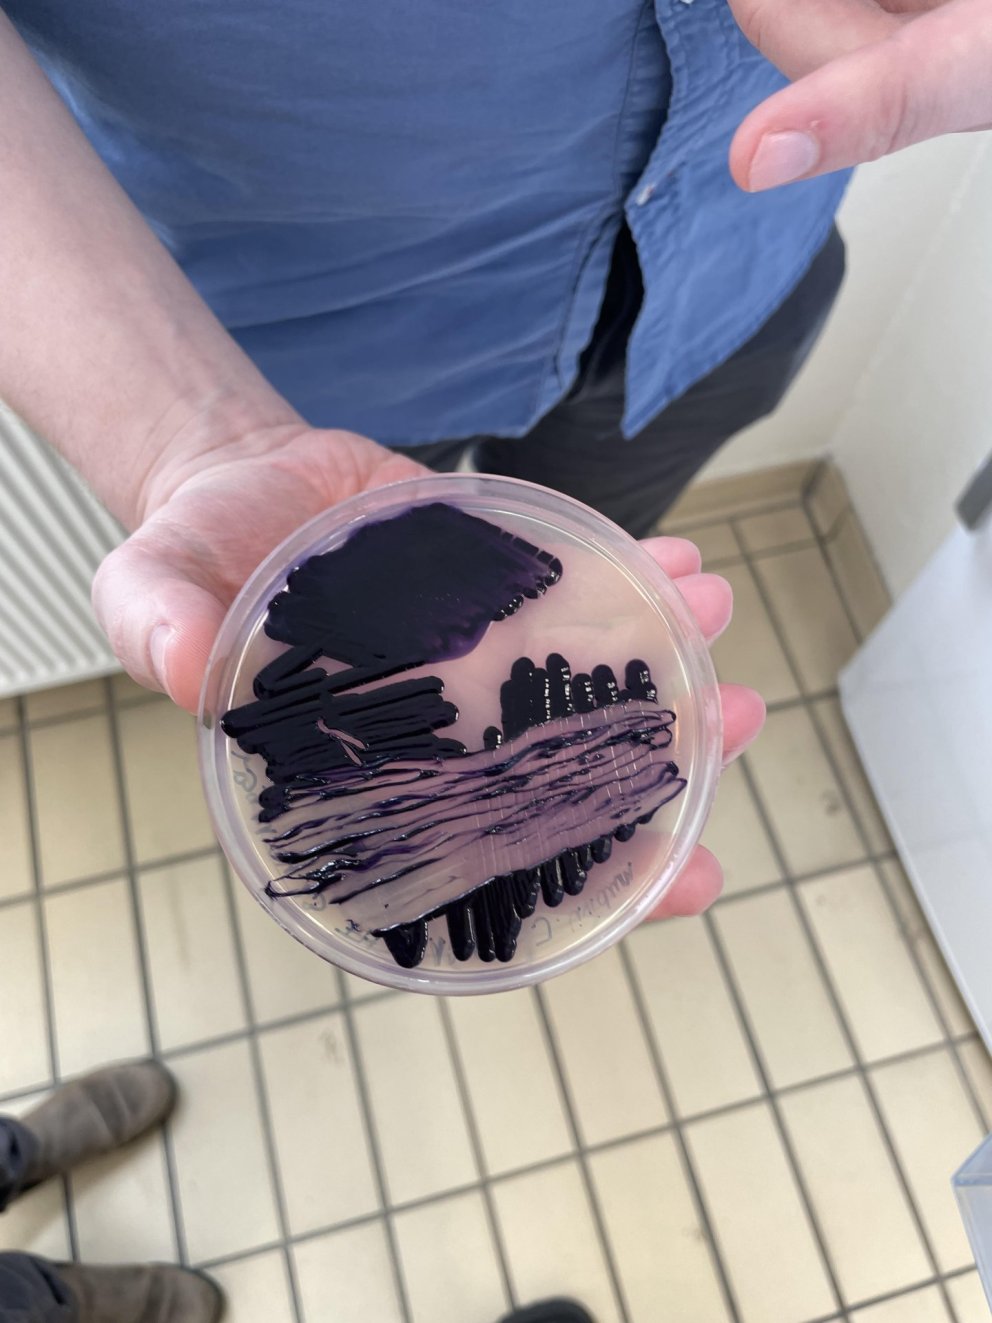

"Living Purple"
Fjólublár - "Living purple" is a research project and collaboration of the Icelandic Textile Center, Biopol and Ístex which received a grant from SSNV in 2023. The main aim is to develop a sustainable dyeing process using the bacterium Janthinobacterium lividum and waste materials.
The project is divided into two parts: Jens Jakob Sigurðarson and Franziska Körber at Biopol have been working on maximising color production since the spring and have been able to produce a strong purple color. Before chemical dyeing, purple was the most expensive color to produce and unaffordable for the average citizen. Today, the textile industry is one of the most polluting industries in the world, also due to chemical dyeing, with terrible consequences for the environment. Dyeing with bacteria, however, is environmentally friendly.
In the beginning of June, Margrét Katrín Guttormsdóttir and Alice Sowa started experimenting with the colour and dyeing Icelandic wool in the Textile Center's TextileLab.
"Living Purple" ends on July 31 - we look forward to seeing the final results!